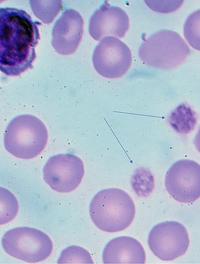

L’immuno-nutrition avant chirurgie du cancer colique a-t-elle un intérêt ?

Nombre de candidats à la chirurgie du cancer colique (KC) sont dénutris. On a accusé les cytokines produites par la tumeur d’entraîner [...]

Nombre de candidats à la chirurgie du cancer colique (KC) sont dénutris. On a accusé les cytokines produites par la tumeur d’entraîner [...]

La fièvre est fréquente chez les nourrissons, elle est due la plupart du temps à des infections virales. Une petite proportion de ces [...]

Depuis près d’une dizaine d’années, les cigarettes électroniques (e-cigarettes) sont devenues l’une des alternatives les plus prisées [...]

Avec 1 400 espèces recensées, les chauves-souris (ordre des Chiroptères), forment le deuxième plus grand ordre de mammifères après [...]

Les formes symptomatiques de l’artériopathie oblitérante des membres inférieurs (AOMI) peuvent retentir considérablement sur la qualité [...]

Selon l’étude Global Burden of Disease 2019 (GBD), l’exposition aux particules fines (PM 2,5) est responsable de 4,1 millions de décès [...]

Il est maintenant admis que les conditions pathologiques respiratoires infantiles voire prénatales interviennent dans la survenue des [...]

La prévalence de la déficience intellectuelle (légère, moyenne ou profonde), est à peu près comparable pour les deux sexes, mais il [...]
Le Purpura thrombopénique immunologique (PTI) est une affection auto-immune avec présence d'auto-anticorps anti-plaquettes, caractérisée [...]

Le diaphragme et les muscles abdominaux jouent un rôle majeur dans la ventilation et dans la régulation de la pression intra-abdominale. [...]

L’encéphalopathie hypertensive est un dysfonctionnement cérébral aigu diffus, dû à une élévation majeure et brutale des chiffres tensionnels, [...]

Chez les adolescents atteints de dermatite atopique sévère, le tralokinumab (anti IL-13) permet de conserver une peau sans lésion ou [...]

Le syndrome de l’intestin irritable (SII), qui touche 10 % de la population, fait partie dans la nouvelle appellation des « désordres [...]

On estime que 1,6 à 3,8 millions d’infections nosocomiales surviennent chaque année dans les maisons de retraite aux États-Unis, entraînant [...]

La transfusion de globules rouges est un traitement commun mais coûteux. Environ 118 millions d’unités de sang sont collectées chaque [...]

Le vieillissement de la population et l’augmentation attendue de la prévalence du déclin cognitif lié à l’âge et de la démence, posent [...]

Les cancers épithéliaux de l’ovaire sont d’un pronostic réservé du fait de leur diagnostic souvent tardif, à un stade déjà évolué qui [...]

Si la France n’a eu d’yeux que pour le casque de protection maxillo-zygomatique du rugbyman Antoine Dupond, une revue se penche sur [...]

Les antibiotiques sont la classe de médicaments la plus utilisée en néonatologie, mais ils sont à l’origine de nombreux effets indésirables, [...]

La vaccination contre le SARS-CoV-2 a montré son efficacité pour réduire les infections, les hospitalisations et la mortalité, mais [...]

L'anticorps monoclonal humanisé ciblant l'IL-23 risankizumab améliore l’état clinique de façon plus prononcée que l'anti-PDE-4 oral [...]

L’incidence croissante des maladies allergiques dans le monde conduit à rechercher des facteurs susceptibles de contribuer à cette [...]

L'utilisation de la morphine à faibles doses (10 à 20 mg/24 h) est utile pour soulager la dyspnée réfractaire de la BPCO (bronchopneumopathie [...]

Les maladies hépatiques chroniques sont un facteur important de mortalité et de morbidité chez les patients infectés par le VIH. Des [...]

La mort subite du nourrisson (MSN) est la mort inattendue d’un enfant de moins de 1 an (MIN) qui reste inexpliquée après une enquête [...]

Le lien entre mauvaise qualité du sommeil et risque cardiovasculaire est déjà connu. Toutefois, la majorité des études ne prennent [...]

L'arthrose des mains peut aboutir progressivement à un handicap sévère qui va perturber les activités de la vie quotidienne et altérer [...]

Les bénéfices de l’activité physique pour les patients atteints de cancer, et dans ses suites, ont été largement démontrés. Elle atténue [...]

La classification radiologique des kystes rénaux, décrite par Bosniak en 1986 et complétée en 2005 comporte 5 catégories (I, II, IIF, [...]

En 2014 la Communauté Européenne a interdit l'utilisation des chlorofluorocarbures (CFC) comme gaz propulseurs dans les aérosols, y [...]